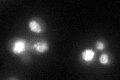
YGR218W
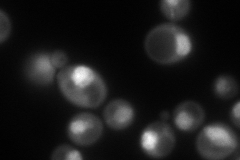
YGR218W
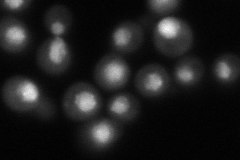
YGR218W
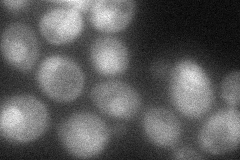
YGR218W

View description
Major karyopherin, involved in export of proteins, RNAs, and ribosomal subunits from the nucleus; exportin
Localization:
Intensity:
Fold change:
Significance:
-
C’ GFP library in SD
nucleus79.11 -
N' NOP1pr-GFP in SD
punctate,nucleus168.963 -
N' TEF2pr-mCherry in SD

cytosol,nucleus360.087 -
N' NATIVEpr-GFP in SD
nucleus125.948 -
N' TEF2pr-VC and Cyto-VN in SD
nucleus57.4284 -
C’ GFP library in SD+DTT

nucleus89.891.13No -
C’ GFP library in SD+H2O2

vacuoleN/AN/ANo -
C’ GFP library in Starvation Media

vacuoleN/AN/AYes -
C’ GFP library on the background of Pup2-DaMP

nucleus -
C’ GFP library on the background of CCT mutant

nucleus116.221.46894Yes
